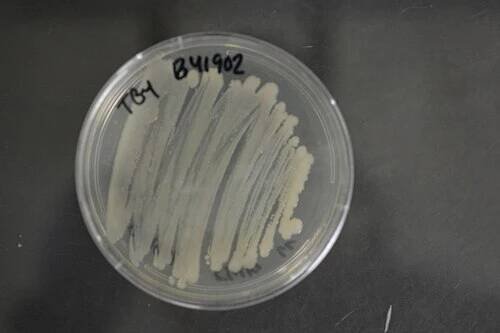

Acinetobacter baumannii
Bakterie
Acinetobacter baumannii je multirezistentní gramnegativní kmen bakterie, vyskytující se zcela běžně v přírodě ve vodě, půdě, či v zdravotnických zařízeních. Pro zdravého člověka nepředstavuje zdravotní nebezpečí, u oslabených, či starých jedinců může avšak vyvolati zápal plic, sepsi a záněty. Tato bakterie vykazuje rezistenci vůči několika doposud známým a obvykle… Wikipedia
Lidé také hledají
Acinetobacter baumannii – Wikipedie
Acinetobacter baumannii je multirezistentní gramnegativní kmen bakterie, vyskytující se zcela běžně v přírodě ve vodě, půdě, či v zdravotnických zařízeních.
Acinetobacter - Wikipedia
Acinetobacter is a compound word from scientific Greek [α + κίνητο + βακτηρ(ία)], meaning nonmotile rod. The first element acineto- appears as a somewhat baroque rendering of the Greek morpheme ακίνητο-, commonly transliterated in English is…
About Acinetobacter | Acinetobacter | CDC
Acinetobacter is a group of germs commonly found in health care and the environment. Good infection control practices can prevent cases.
Acinetobacter baumannii - Wikipedia
While other species of the genus Acinetobacter are often found in soil samples (leading to the common misconception that A. baumannii is a soil organism, too), it is almost exclusively isolated from hospital environments. [3 ] Although…
Bakterie Acinetobacter a její význam pro zdraví | frequenz…
Bakterie Acinetobacter patří do skupiny mikroorganismů, které se vyskytují v různých prostředích , včetně půdy, vody a také ve zdravotnických zařízeních.
Genetická diverzita a fylogeneze rodu Acinetobacter v…
Rod Acinetobacter zahrnuje fyziologicky a biochemicky heterogenní skupinu bakterií značně rozšířených v přírodě. I přes pokrok, kterého bylo dosaženo v klasifikaci humánních izolátů acinetobakterů, máme jen velmi málo informací o diverzitě…
Acinetobacter – serious danger FOR burn patients | proLékaře.cz
Acinetobacter was described for the first time by Beijerinck as Micrococcus calco-aceticus (Beijerinck 1911), while a detailed study was presented later by Baumann et al. in 1968 and Bouvet and Grimont in 1986 (2, 7).
odkazuje na služby nejen od Seznam.cz.
© 1996–2025 Seznam.cz, a.s.